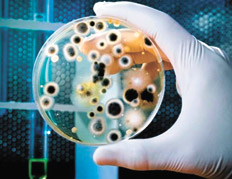

![]()
![]()
![]() Lunes, 4 de julio de 2016
| Hoy
Lunes, 4 de julio de 2016
| Hoy
SOCIEDAD › EL CONICET INVESTIGA BACTERIAS CAPACES DE GENERAR ELECTRICIDAD Y DESCONTAMINAR AGUA
Las malas de la película eran buenas
Obtienen electricidad y descontaminan agua a partir de bacterias. El nuevo dispositivo genera bioenergía, a la vez que puede limpiar aguas residuales, ya que degrada materia orgánica. Se trata de una aplicación sustentable y económica.
 Por Nicolás Camargo Lescano *
Por Nicolás Camargo Lescano *
Entre tantas enfermedades y publicidades de desinfectantes, las bacterias se ganaron el rol de “villanas” en la vida cotidiana. Pero, ¿qué pasaría si, por un rato, se convirtieran en piezas claves de un circuito que brinda energía eléctrica? ¿Y si, además, en forma simultánea, pudieran descontaminar aguas residuales?
Hacia ese doble desafío apuntan investigadores del INTEMA (CONICET-UNMdP), quienes desarrollaron electrodos con los que puede obtenerse bioenergía, es decir, energía a partir de organismos vivos. “La idea de la que partimos es que existe cierto tipo de bacterias que degradan materia orgánica, por ejemplo las bacterias conocidas como Geobacter sulfurreducens. En este proceso, dichas bacterias ceden electrones a los sustratos sobre los que crecen y se desarrollan”, explica Hernán Romeo, doctor en Ciencia de Materiales e integrante del proyecto.
Para poder aprovechar estos electrones y así generar corriente eléctrica, el material sobre el que las bacterias están depositadas debe ser conductor de la electricidad (es decir, debe actuar como un electrodo). Pero los investigadores debían resolver un problema: las bacterias tienden a “apilarse” y formar múltiples capas sobre dicho material, en un proceso conocido como estratificación fisiológica. Por tal motivo, una gran cantidad de electrones nunca llegaba al electrodo y la corriente obtenida era menor que la que potencialmente se podía obtener.
¿Cuál fue la solución de los investigadores? Diseñar materiales porosos con una gran superficie disponible para el crecimiento de las bacterias, evitando que éstas se apilen. Así fue como los investigadores desarrollaron “edificios” para las bacterias, tal como lo explica Romeo. “Necesitábamos que la mayor cantidad de bacterias posibles estuviera en contacto con la mayor cantidad de superficie posible. Fue así que diseñamos electrodos porosos, hechos con un óxido de titanio conductor de la corriente, de forma tal que cada bacteria tuviera su lugar o su ‘habitación’ en el electrodo, asegurándonos que un gran número de microorganismos estuviera en contacto con el material conductor”, señala el investigador del CONICET.
El desarrollo del electrodo implicó mejoras no sólo en la conductividad eléctrica del material, sino también en su geometría interna y su estabilidad mecánica, llegando a alcanzar niveles de porosidad de hasta el 90 por ciento. El trabajo dio sus frutos, ya que los niveles de corriente obtenidos por los investigadores están entre los más altos reportados a nivel mundial. “De todas maneras –aclara Romeo– este proceso lo llevamos a cabo a escala laboratorio. El gran desafío futuro es incrementar el tamaño del electrodo y de este modo logran aumentar la corriente generada para poder utilizarlo en aplicaciones de interés tecnológico”.
Un aliado
El proyecto del INTEMA se enmarca dentro de los dispositivos conocidos como Celdas de Combustible Microbianas. “Básicamente, estas celdas son pilas. El electrodo poroso que estamos haciendo sería una parte fundamental para que esa pila funcione”, subraya Romeo. El desarrollo y optimización de estas Celdas se utilizaría no sólo para la generación de corriente eléctrica, sino también para la limpieza de agua residual.
“Al hacer pasar el agua residual por la celda o pila –detalla el investigador–, las bacterias degradarían la materia orgánica y al mismo tiempo que generan corriente eléctrica pueden descontaminar el agua. Obtendríamos corriente eléctrica a partir de agua de desechos”.
El proyecto, financiado por la Fundación Argentina de Nanotecnología, fue seleccionado dentro de los trabajos finales en los Premios INNOVAR 2015. Entre los próximos objetivos, los científicos buscan lograr un vínculo más estrecho con el sector de la industria, para poder darle un mayor impulso al proyecto.
“Desde luego, siempre hay colaboraciones. A veces pareciera que la idea se le ocurrió a alguna persona en particular, y en realidad es consecuencia del trabajo de mucha gente durante muchos años. La producción de electrodos cada vez más eficientes es todo un desafío, pensando en aplicaciones sustentables y económicamente rentables”, concluye Romeo. El equipo de trabajo está integrado además por Juan Pablo Busalmen, Diego Masazza y Rodrigo Parra.
* Agencia CTyS-UNLaM.
-
MARCHAS Y RECLAMOS DE PUEBLOS ORIGINARIOS CONTRA EL BICENTENARIO
“No tenemos nada que celebrar”
Por Darío Aranda -
TRASLADAN A RíO GRANDE AL DETENIDO POR EL DESCUARTIZAMIENTO DE NILDA NúñEZ
Un femicidio anunciado
Por Horacio Cecchi - Otro violento detenido
-
AMANCAY, LA BALLENA FRANCA VARADA EN LA COSTA RIONEGRINA, MURIó LUEGO DE OCHO DíAS
El mar no la llevó de vuelta -
MURIó DE VIEJO EL OSO DEL ZOOLóGICO DE MENDOZA
El oso Arturo no está más -
EL CONICET INVESTIGA BACTERIAS CAPACES DE GENERAR ELECTRICIDAD Y DESCONTAMINAR AGUA
Las malas de la película eran buenas
Por Nicolás Camargo Lescano -
LA LEY QUE CREA EL CONSEJO DE LA PROPIEDAD HORIZONTAL
El Suterh propone un nuevo debate - Apertura ilegal
- Arrollado por el colectivo
- Avanza la gripe A
- El opio en EE.UU.
- Preocupación por el Atuel
- Buscan a un chico de 13
ESCRIBEN HOY
- Alejandra Dandan
- Cristian Vitale
- Darío Aranda
- Eduardo Aliverti
- Federico Lisica
- Gabriela Gervasoni
- Horacio Bernades
- Horacio Cecchi
- Juan Sasturain
- Laura Vales
- Leandro Arteaga
- Leo Ricciardino
- Leonel Lenga
- Lorena Panzerini
- Mempo Giardinelli
- Mónica Peralta Ramos
- Natalia Aruguete y Bárbara Schijman
- Nicolás Camargo Lescano
- Pablo Fornero
- Silvina Friera
- Sonia Santoro
© 2000-2022 www.pagina12.com.ar | República Argentina | Política de privacidad | Todos los Derechos Reservados
Sitio desarrollado con software libre GNU/Linux.






